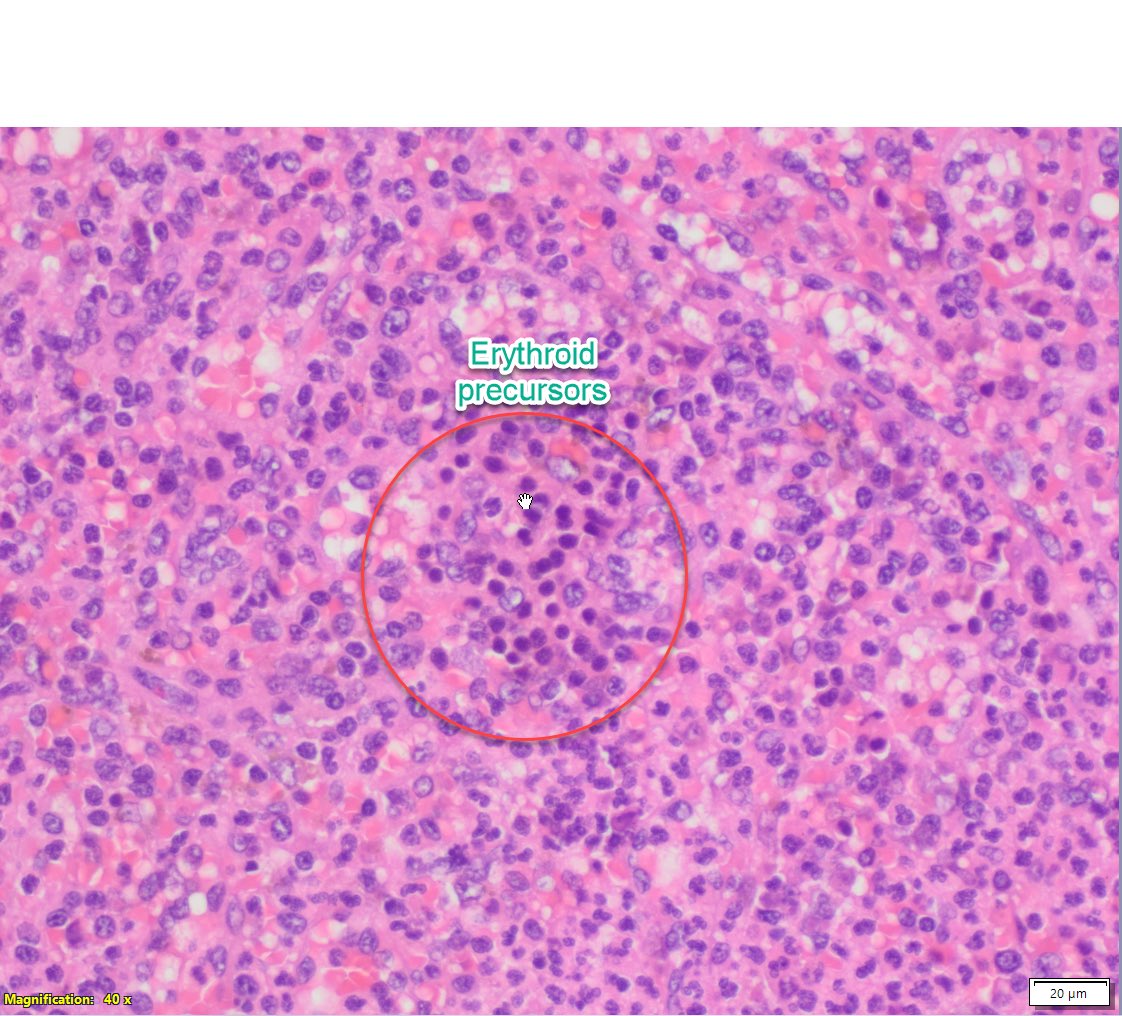
sanamloghavi's tweet image. We rarely see #splenectomy specimens anymore but when we do.. it’s glorious. This #spleen from a pt with autoimmune hemolytic anemia read the textbooks!shows extramedullary hematopoiesis, increased neutrophils, red pulp congestion and hemophagocytosis. #hemepath at its best!!!

#splenectomy arama sonuçları
Patient registry cuts rates of post-splenectomy complications, but more research is needed. | #patientregistry #spleen #splenectomy @ITPSupportAssoc | contagionlive.com/link/820

February Issue: Laparoscopic Subtotal #Splenectomy : A Feasible Option in the Treatment of #SplenicMetastasis @AlbertoGPicazo @IelpoB @FBurdio rdcu.be/ebqTK @cchildersmd @SyedAAhmad5
ow.ly/qMPS50wx6mS Diagnostic value of post-operative platelet-to-white blood cell ratio after #splenectomy in patients with advanced #OvarianCancer #GynOnc #Surgery @ESGO_society @IGCSociety @GynMe4
Dr Amber Yates notes that it’s important to discuss #splenectomy as a treatment for enlarged spleen or severe #anemia in PKD: “It’s not for every patient. We’ve learned through the years that just removing your spleen is not that simple...that there is an infection risk...”

#Splenectomy is the only unequivocal curative treatment of immune #thrombocytopenic Purpura #HemaSphere ow.ly/FrUF30lZBZX

Real-World Evidence for ITP Treatment ow.ly/I2Bm50vCgsy #HematologicMalignancies #therapy #splenectomy #azathioprine #immune

Read about impacts of #splenectomy in #ovarian cancer on #morbidity and #survival 📌 bit.ly/3NmUNkH @housseinelhajj3 @pedroramirezMD @HsuMd @JayrajAarthi @AndreFernandes2 @agz_eriksson @IGCSociety @ESGO_society @ENYGO_official @OncoAlert @IJGCfellows @GynMe

“Cholecystectomy” was the answer to our quiz yesterday. For people with #PKdeficiency, removing the gallbladder at the time of #splenectomy may help avoid a separate, additional surgery.

A manuscript published in #JAVMA found that benign splenic lesions were uncommon in a cohort of cats. 🐈 Learn more: jav.ma/splenic @TheACVS @ACVIM @TheACVR #feline #splenectomy #mastcelltumor #hemangiosarcoma #hemoabdomen

Perioperative ventricular arrhythmias (VAs) were common in dogs undergoing #splenectomy for splenic masses, and the odds of VAs were increased with #hemoperitoneum, increasing heart rate, and increasing body weight: jav.ma/va @theacvs @ugavetmed #mortality #canine🐶

#AudioVisualAbstract : Time Trend Analysis of #Splenectomy for Splenic Marginal Zone #Lymphoma : Declining Surgery, Promising Survival rdcu.be/dHMUo @SyedAAhmad5 @CamilleLStewart
228 Responses in 2022 - 204 responses in 2021 - At the Sylvester O Halloran #soh2022, #Splenectomy / #Thoracotomy / #Dualconsultantoperating The Sylvester Shouter, surgical community has spoken - @barb_julius @colettecowan1 @RCSI_Irl @ShouterSoh
An Australian study found patients were better informed & more empowered when they signed up for a national registry of spleen disease patients. #spleen #splenectomy @CllSociety contagionlive.com/link/820

Annie is recovering so well from her emergency #splenectomy and I’m soaking up all the love I can! 🥰 #beyondgrateful #14yearoldpuppy

#5goldrings Locate where you would have a #Splenectomy ? I’ve no idea - and I’m embarrassed to say I’ve had a Splenectomy 🥴 I swapped it for #Claudiawinklemans hair

- بحمد الله و توفيقه تم استئصال طحال متضخم بنجاح لمريض مصاب بالثلاسيميا .. اللهم سخرنا لخدمة المرضى و اعف عنا حتى ترضى 🙏🏻 #Splenectomy for #Thalassemia patient. @ مستشفى النور التخصصي… instagram.com/p/BqKkb3UndnE/…
Are the current treatment guidelines for chronic immune thrombocytopenia cost-effective? Learn more: doi.org/10.1002/ajh.26… @GeorgeGoshuaMD @LaurenPischel #hematology #rituximab #splenectomy

We rarely see #splenectomy specimens anymore but when we do.. it’s glorious. This #spleen from a pt with autoimmune hemolytic anemia read the textbooks!shows extramedullary hematopoiesis, increased neutrophils, red pulp congestion and hemophagocytosis. #hemepath at its best!!!



•RBCs with basophilic nuclear remnantsdescribes Howell-Jolly bodies and can be seen in patients who have had a #splenectomy or patients with functional asplenia.

Upper left abdominal pain or repeated infections? Minimally invasive spleen surgery offers less pain, smaller scars, and faster recovery. Consult Dr. Randeep Wadhawan today. 📞 +91 7042373880 #LaparoscopicSurgery #Splenectomy #MinimalAccessSurgery #DrRandeepWadhawan

Need surgery to remove the spleen? Laparoscopic Splenectomy offers smaller cuts, less pain & faster recovery — for suitable patients. Safer. Quicker. Better healing. 📞 +91 7042373880 🌐 randeepwadhawan.com #LaparoscopicSurgery #Splenectomy #MinimalInvasive #GISurgery

Ms. Shainaya Gupta from Kanpur, with Thalassemia and a 2 kg enlarged spleen, underwent a successful splenectomy under Dr. Saad Anwar at Paras Health – Kanpur and is recovering well. 📞 8080808069 #ParasHealth #Thalassemia #Splenectomy #PatientStory
#Techniquetuesday Highlighting ‘#Laparoscopic #Splenectomy and #Cholecystectomy for #Spherocytosis' by Dr. Sherif Emil. Library of surgical technique videos in the @StayCurrentMD app! Video: staycurrentmd.pulse.ly/ut1c0vddxc #SoMe4PedSurg Made possible by @CincyChildrens
Life After Splenectomy: Amblal Parmar’s Inspiring Journey at Shalby Hospital Ahmedabad - youtube.com/watch?v=lGMnAe… For expert consultation call us at: 7069001001 #splenectomy #LiverCirrhosis #livercirrhosistreatment #surgery #livertreatment #gastrointestinal #treatment
youtube.com
YouTube
Life After Splenectomy: Amblal Parmar’s Inspiring Journey at Shalby...
An openaccess research: "Hairy Cell Leukemia With Splenic Rupture: Hematological Changes and Disappearance of Hairy Morphology After Splenectomy" published by Journal of Hematology. jh.elmerpub.com/jh/article/vie… Keywords: #Hairy cell #leukemia, #Splenectomy, Hairy cell #morphology


Featured: Laparoscopic Subtotal #Splenectomy : A Feasible Option in the Treatment of #SplenicMetastasis . ow.ly/7zM350WyQIy @nedamini @SyedAAhmad5

#Splenectomy can be an alternative treatment for refractory #Myelodysplasia syndrome (#MDS) with #splenomegaly Full article: 📄 Udayana Journal of Internal Medicine jpdunud.org/index.php/JPD/…
Hairy Cell Leukemia With Splenic Rupture: Hematological Changes and Disappearance of Hairy Morphology After Splenectomy jh.elmerpub.com/jh/article/vie… Keywords: Hairy #cell #leukemia; #Splenectomy; Hairy cell #morphology




We're highlighting ‘#Laparoscopic #Splenectomy & #Cholecystectomy for #Spherocytosis' by Dr. Sherif Emil. Check out our video library of surgical technique videos in the @StayCurrentMD app! Full vid: youtu.pulse.ly/zzieh3ctua #SoMe4PedSurg Made possible by @CincyChildrens
Early mobilization and delayed arterial ligation (EMDAL) as a surgical technique for splenectomy and shunt surgery in portal hypertension 🌷doi.org/10.14701/ahbps… 2024 Feb;28(1)Harilal S L, #Portal_hypertension #Splenectomy #Esophageal_and_gastric_varices #Cirrhosis

Excited to share our newly published case report in the @ACGCRJ on #splenosis in a post-trauma #splenectomy patient presenting with gynecologic complaints. Certainly a challenging diagnosis to keep in mind in this #trauma patient population. Link: doi.org/10.12659/AJCR.…


لما تشيل للعيان الspleen اديله قبلها vaccine وبعدها بنسلين( penicillin ) #splenectomy
We rarely see #splenectomy specimens anymore but when we do.. it’s glorious. This #spleen from a pt with autoimmune hemolytic anemia read the textbooks!shows extramedullary hematopoiesis, increased neutrophils, red pulp congestion and hemophagocytosis. #hemepath at its best!!!

Read about impacts of #splenectomy in #ovarian cancer on #morbidity and #survival 📌 bit.ly/3NmUNkH @housseinelhajj3 @pedroramirezMD @HsuMd @JayrajAarthi @AndreFernandes2 @agz_eriksson @IGCSociety @ESGO_society @ENYGO_official @OncoAlert @IJGCfellows @GynMe

In Press | Simultaneous splenectomy improves outcomes after adult living donor liver transplantation. bit.ly/31xkszi #transplant #Splenectomy

Vascular Anatomy of the Spleen: (𝗮) 𝗗𝗶𝘀𝘁𝗿𝗶𝗯𝘂𝘁𝗲𝗱 type with multiple splenic notches, & (𝗯) 𝗠𝗮𝗴𝗶𝘀𝘁𝗿𝗮𝗹 type with few splenic notche 𝗥𝗲𝗳:Advanced Laparoscopic Surgery, Techniques & Tips, 2nd Edition. #splenectomy #GITwitter



📄 New Infographic! "Partial splenectomy in children: Long-term reoperative..." Hafezi et al. Full article: jpedsurg.org/article/S0022-… Infographic created by @EmTombash @emencisco @RodGerardo #SoMe4PedSurg #pediatricsurgery #splenectomy #JPS

Safely de-livered! A meta-analysis of simultaneous #LiverTransplantation & #splenectomy assesses the efficacy & safety of the procedures; careful patient selection is vital. @MIbnosina recommends the study by He C et al. published in @MedicineLWW facultyopinions.com/prime/73281746…

New article from @ClevelandClinic! #Splenectomy outcomes in immune cytopenias: Treatment outcomes and determinants of response. 🔗doi.org/10.1111/joim.1… @ccfhemeonc @olisaogbue @Bahaj_MD #Hematology

📄New Infographic! "Partial splenectomy in children: Long-term reoperative..." Hafezi et al. Full article: jpedsurg.org/article/S0022-……… Infographic created by @EmTombash @emencisco @RodGerardo #SoMe4PedSurg #pediatricsurgery #splenectomy #JPS

Are the current treatment guidelines for chronic immune thrombocytopenia cost-effective? Learn more: doi.org/10.1002/ajh.26… @GeorgeGoshuaMD @LaurenPischel #hematology #rituximab #splenectomy

This is how my belly looks now after my surgery, mom says it’s like a cow’s belly 😹—Umi, tuxedo cat. #splenectomy #tuxedocat

Perioperative ventricular arrhythmias (VAs) were common in dogs undergoing #splenectomy for splenic masses, and the odds of VAs were increased with #hemoperitoneum, increasing heart rate, and increasing body weight: jav.ma/va @theacvs @ugavetmed #mortality #canine🐶

#5goldrings Locate where you would have a #Splenectomy ? I’ve no idea - and I’m embarrassed to say I’ve had a Splenectomy 🥴 I swapped it for #Claudiawinklemans hair

Dr Aceng stated, 1990: the late Speaker had a #splenectomy after an assault during a student demo' 2019: cancer found in his neck 2022: his bone marrow cld no longer make blood cells to fight infections & stop bleeding, he got multiple infections & abdominal bleeding. A tragedy.


In 2019, Jacob Oulanyah discovered a swelling in the neck. It was a relatively big swelling and he took it upon himself to seek treatment in Germany. The swelling was removed and analysed and he was told it was cancer. -Health Minister Jane Ruth Aceng. #NTVNews

🅐︎ Classification of splenomegaly based on CT or post-resection weight 🅑︎ Patient Selection for Laparoscopic,Hand-Assisted Laparoscopic,or Open Approach 🅒︎Preoperative Splenic Artery Embolization 𝗥𝗲𝗳:Maingots abdominal surgery #splenomegaly #MedTwitter #splenectomy




Something went wrong.
Something went wrong.
United States Trends
- 1. Skenes N/A
- 2. Cruz N/A
- 3. #OpeningDay N/A
- 4. Mets N/A
- 5. Pirates N/A
- 6. Carson Benge N/A
- 7. Kevin McGonigle N/A
- 8. Brandon Lowe N/A
- 9. Druski N/A
- 10. Justin Crawford N/A
- 11. JJ Wetherholt N/A
- 12. #STLCards N/A
- 13. Ben Brown N/A
- 14. Kyle Schwarber N/A
- 15. Cubs N/A
- 16. Pivetta N/A
- 17. Trevor Rogers N/A
- 18. Joe Ryan N/A
- 19. Erika Kirk N/A
- 20. Boyd N/A













































